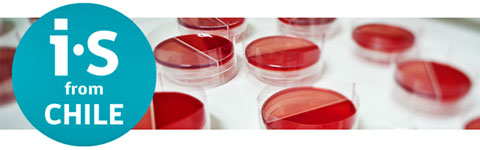
imagen-web

Del 22 al 24 de Octubre próximo se realizará el Encuentro de Industrias y Servicios I.S From Chile- México 2013, un evento de carácter empresarial donde 35 empresas chilenas se reunirán con compradores de toda la reRepública de México, en busca de nuevas oportunidades comerciales en los sectores mencionados.
El evento será inaugurado el martes 22 de octubre en punto de las 09:00 horas, dentro de las instalaciones en el Hotel W de Polanco, por el Embajador de Chile en México, Adolfo Carafi, el Ministro de Economía de México, Ildefonso Guajardo Villareal y altos ejecutivos de ProChile y ProMéxico, quienes se referirán a la relación comercial entre ambos países y las oportunidades empresariales que significa la realización de este tipo de encuentros.
Durante la mañana del miércoles 23 se realizarán las reuniones de negocios. Así mismo, en el Hotel W, la delegación chilena de 35 empresas, compuestas por empresas de Tecnologías de la Información (14), Audiovisual (3), Vestuario (9), Calzados (2), Plásticos (2) y Cosméticos (2), sostendrán reuniones de negocios con sus pares mexicanos, teniendo la posibilidad de analizar y concretar nuevos negocios, explorando el potencial y complementaridad que tienen ambas economías.
México es la segunda economía más grande de América Latina. Cuenta con un atractivo ambiente de negocios, certidumbre jurídica, una de las mayores redes de acuerdo de libre comercio en el mundo, así como sectores económicos con amplios desarrollos y un perfil de costos altamente competitivos.
Hoy en día, México y Chile son los únicos países latinoamericanos miembros de la Organización para la Cooperación y el Desarrollo, OCDE formando parte también de la Alianza del Pacífico. A través de este evento, Chile busca mostrar la capacidad productiva y la gestión eficiente de sus empresas en los ámbitos señalados, capaces de dar soluciones integrales a todo el canal de comercialización, con productos y servicios de calidad que cumplen con los requerimientos de los más exigentes mercados internacionales.
En el marco de este encuentro de negocios, en la noche del 23 de octubre, en el Museo Soumaya, se presentará una pasarela de modas donde las empresas y/o diseñadores de la industria de la moda chilena (11), presentarán sus colecciones a potenciales compradores mexicanos.
Entre los diseñadores Chilenos que estarán presentes se encuentran Juanita León y Paulo Méndez, dos profesionales elegidos por Coca-Cola para crear la nueva imagen de sus latas de bebida light en Chile; Luz Briceño, experimentada creadora Chilena que ha demostrado sus colecciones en mercados como Nueva York y Japón, y creadora del primer gremio de la industria de la moda en Chile, Atilio Andreoli, quien ha vestido a los últimos cuatro presidentes chilenos, entre otros profesionales de calzado de autor y accesorios.
A continuación, el programa completo.
Lunes 21 de octubre. De 16:45 a 17:45 horas.
Andrés Bello 10, Piso 18, Polanco.
Martes 22 de octubre. De 08:00 a 18:00 horas.
Hotel W. Evento de Sesión Plenaria y Talleres Sectoriales.
Miércoles 23 de Octubre. De 08:00 a 23:00 horas.
Museo Soumaya. Showroom TI/ Ruedas de negocios. Pasarela de Moda.
Jueves 24 de octubre. De 08:00 a 13:00 horas.
Santa Fe, ciudad de México. Experience share para el sector TI en el ITSM CSF. Ruta de la moda.
Para mayores informes:

























